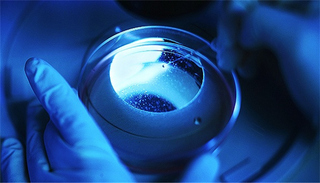

由中国细胞生物学干细胞生物学分会主办,中科院干细胞与再生创新研究院承办的《干细胞通用要求》新闻发布会11月22日在北京举行。
发布会现场,中国细胞生物学干细胞生物学分会会长周琪院士介绍了干细胞通用标准制定背景,宣布《干细胞通用要求》正式出版发行。
“《干细胞通用要求》是根据国家标准委2017年发布的《团体标准管理规定》制订的首个针对干细胞通用要求的规范性文件,将在规范干细胞行业发展,保障受试者权益,促进干细胞转化研究等方面发挥重要作用。”周琪指出。
据干细胞通用标准工作组组长赵同标研究员介绍,该标准是在中国细胞生物学学会干细胞生物学分会领导下,由北京干细胞库、中国标准化研究院和中国计量科学研究院等单位参照国内外相关规定,并征询干细胞领域多方专家的建议共同起草制订,经广泛征求意见,最终修订发布。
干细胞是一类能够自我更新、具有多向分化潜能的细胞,能用于治疗多种疾病。尽管我国已出台系列管理文件,规范干细胞基础研究与转化领域的发展,但由于干细胞来源多样、制备工艺复杂、质控和监管困难,干细胞的临床应用和产业化面临巨大挑战。
2016年,干细胞生物学分会组织干细胞领域专家和标准工作专家正式成立了干细胞标准工作组,并着手制订相关标准。该标准制订过程中召集了标准工作的相关单位和组织,综合考虑国内外进展、行业协同、基础研究、临床转化等因素,形成了干细胞领域的基本共识。
该标准围绕干细胞制剂的安全性、有效性及稳定性等关键问题,建立了干细胞的供者筛查、组织采集、细胞分离、培养、冻存、复苏、运输及检测等的通用要求,将有力地推动干细胞领域的规范化和标准化。
“在国家标准发布之前,作为团体标准的《干细胞通用要求》的出版,可以为从事干细胞研究,包括干细胞研发机构、备案医院和干细胞库建设的人们提供具有国际水准的、已达成行业共识的、专业的参考和依循。”国家卫计委科教司技术处处长王锦倩表示。
“针对药品安全、有效、质量可控的要求,出台该标准,将对干细胞生产者具有很好的借鉴意义和实际应用价值。”国家食药总局药审中心高级审评员韦薇指出。
出席新闻发布会的北京大学人民医院代表也表示,干细胞通用标准在业界是领先的,希望实验室成果能够及早实现临床转化,使得一些疾病治疗取得突破。
国家卫生与计划生育委员会、国家食品药品监督管理总局药品审评中心、中国科学院、中国科学技术协会、中国生物技术发展中心、中国食品发酵工业研究院、中国细胞生物学学会等部门代表、干细胞标准工作组和用户代表出席了发布会。
